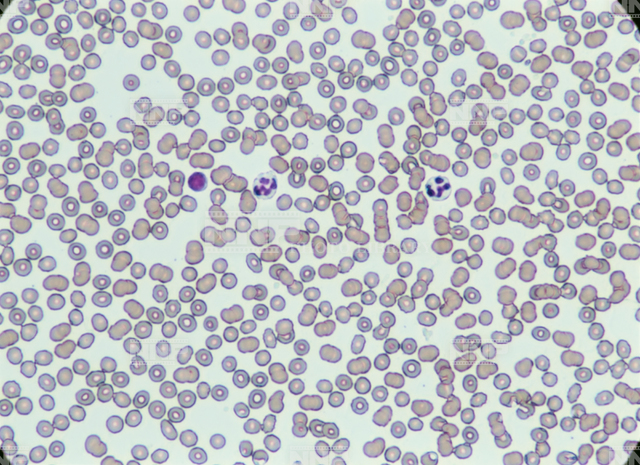

0077A24636
ギムザ染色 顕微鏡倍率200倍
6000px × 4360px
11.0 MB (展開 74.8MB)
ギムザ染色 顕微鏡写真 白血球 赤血球 人間 血液
取得されていません
取得されていません
※キャプション、キーワード、説明等の正確性については保証いたしかねます。
ご利用の前に必ず再確認をお願いいたします。
閉じる
| 使用媒体 | 料金(消費税別) | |
|---|---|---|
| カレンダー | 1枚 | 60,000 |
| 枚数 | 50,000 | |
| 卓上 | 30,000 | |
| ポスター | 1枚 | 60,000 |
| 中吊り | 50,000 | |
| ディスプレイ・パネル・看板・POP | 3m2超 | 70,000 |
| ~3m2 | 70,000 | |
| ~1m2 | 50,000 | |
| ~0.25m2 | 30,000 | |
| ジャケット・ステッカー・パッケージ・包装紙・紙袋・封筒 | 40,000 | |
| パンフ・カタログ・PR誌・業界誌・社内報・会社案内 | 表紙 | 40,000 |
| 中頁 | 30,000 | |
| ちらし・リーフレット | 30,000 | |
| CF(テレビCM含む) | 1局1クール | 50,000 |
| 映画 | 1作品 | 50,000 |
| テレビ番組 | 1作品1放映 | 25,000 |
| メディア内映像(BD・DVD・CD) | 35,000 | |
| インターネット | ~12ヶ月 | 40,000 |
| ~6ヶ月 | 30,000 | |
| ~3ヶ月 | 25,000 | |
| ~1ヶ月 | 20,000 | |
| 新聞広告 | ~15段 | 80,000 |
| ~10段 | 60,000 | |
| ~7段 | 40,000 | |
| 雑誌広告 | 表2、3、4 | 50,000 |
| 中頁 | 40,000 | |
| 書籍 | 表1 | 35,000 |
| 表2、3 | 25,000 | |
| 表4 | 30,000 | |
| 中頁 1/2P以上 | 20,000 | |
| 中頁 1/2P未満 | 15,000 | |
| 中頁 外国写真 | 20,000 | |
※特別写真、航空写真には、特別料金10,000円が加算されます。
※使用媒体『書籍』に限り、1色・2色使用の場合は上表該当料金の70%となります。
※本使用に至らない、カンプ画像のプレゼンテーション等へのご使用およびポジマウントの開封につきましては
プレゼンテーション料5,000円が発生いたします。
※本データ画像のダウンロード後にご使用をキャンセルされた場合は、キャンセル料5,000円が発生いたします。
※ご請求書発行後のキャンセルの場合は、ご請求料金の70%をキャンセル料としてお支払いいただきます。
※無断使用、虚偽申請による使用は不正使用とみなし、上表該当料金の5倍の金額を 違約金としてお支払いいただきます。
※ポジフィルムを紛失・破損した場合は、50万円を上限に補償料をお支払いいただきます。
※ご請求金額は、上記金額に消費税8%を加算した金額となります。
本サイトに掲載の全てのコンテンツは著作権法により無断使用は固く禁じられています。
